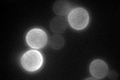

View description
Putative protein of unknown function; the authentic, non-tagged protein is detected in a phosphorylated state in highly purified mitochondria in high-throughput studies; transcriptionally regulated by Haa1p
Localization:
Intensity:
Fold change:
Significance:
-
C’ GFP library in SD

cell periphery102.57 -
N' NOP1pr-GFP in SD

ER128.776 -
N' TEF2pr-mCherry in SD

ER105.975 -
N' NATIVEpr-GFP in SD

ER32.8082 -
N' TEF2pr-VC and Cyto-VN in SD

below threshold24.9421 -
C’ GFP library in SD+DTT

cell periphery124.421.21No -
C’ GFP library in SD+H2O2
cell periphery132.731.29No -
C’ GFP library in Starvation Media

cell periphery333.633.25Yes -
C’ GFP library on the background of Pup2-DaMP

cell periphery -
C’ GFP library on the background of CCT mutant

cell periphery79.11810.771271No
